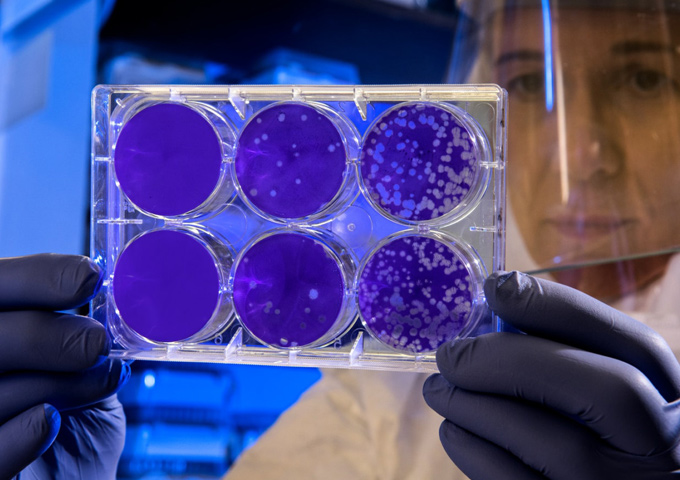
Future Earth

Is science enough? Just how many sustainability superheroes will it take to save the planet?
We are living in an era of change, a new dawn of time where humanity’s impact on earth is more profound than ever before. The time has come to step back from the precipice, protect what remains and move toward solutions for surviving and thriving on this extraordinary planet.
Future Earth needs us.
To succeed in bringing humanity back from the brink we need great minds, a collective force, shared knowledge, and a global transdisciplinary approach to sustainable existence on Earth.
Join National Science Week Queensland on a journey to discover all that is possible in creating a brilliantly bright and sustainable future through science. Unlocking the past, present and ‘future normal’ of life on earth through science.
Live Stream Conversations
Factory of the Future: Where technology meets the everyday
Tuesday 18 August, 6:00 – 7:00 pm
Smart or not, the future will still need factories to make the stuff we humans use everyday. How will existing production models cope with the staggering and ongoing rate of digital disruption and advanced capabilities?
Dial in to hear three innovation leaders blow your mind as they predict the future of manufacturing and how the human worker fits into this fast-changing landscape.
Pandemic Proofing: Facing the new normal
Wednesday 19 August, 6:00 – 7:00 pm
With global COVID-19 infection and death rates still rising, the world is looking to science. We need a protective vaccine in the short term, as we are struggling with current strategies for mitigating the risk and severity of this new and dangerous viral disease.
Our infectiously talented panel of experts will discuss how this crisis could change our lives forever, and whether we can ever pandemic-proof the future.
The Future is in Their Hands: Tread softly, with purpose and courage
Thursday 20 August, 10:00 – 11:00 am
Growing up is tough enough! Add the knowledge and threat of climate catastrophe and you have Generation Z, a cohort of young adults with an enormous degree of eco-anxiety to manage.
In the name of hope, we give voice to three inspiring young changemakers and their creative solutions for surviving and thriving on the future planet Earth.






